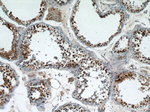
PRPF39 Antibody in Immunohistochemistry (Paraffin) (IHC (P))

Search
Proteintech
PRPF39 Polyclonal Antibody
{{$productOrderCtrl.translations['antibody.pdp.commerceCard.promotion.promotions']}}
{{$productOrderCtrl.translations['antibody.pdp.commerceCard.promotion.viewpromo']}}
{{$productOrderCtrl.translations['antibody.pdp.commerceCard.promotion.promocode']}}: {{promo.promoCode}} {{promo.promoTitle}} {{promo.promoDescription}}. {{$productOrderCtrl.translations['antibody.pdp.commerceCard.promotion.learnmore']}}
产品信息
24480-1-AP
种属反应
宿主/亚型
分类
类型
抗原
偶联物
形式
浓度
规格
纯化类型
保存液
内含物
保存条件
运输条件
产品详细信息
Immunogen sequence: MEQSPDDSP NVNASTEETE MASAVDLPVT LTETEANFPP EYEKFWKTVE NNPQDFTGWV YLLQYVEQEN HLMAARKAFD RFFIHYPYCY GYWKKYADLE KRHDNIKPSD EVYRRGLQAI PLSVDLWIHY INFLKETLDP GDPETNNTIR GTFEHAVLAA GTDFRSDRLW EMYINWENEQ GNLREVTAIY DRILGIPTQL YSHHFQRFKE HVQNNLPRDL LTGEQFIQLR RELASVNGHS GDDGPPGDDL PSGIEDITDP AKLITEIENM RHRIIEIHQE MFNYNEHEVS KRWTFEEGIK RPYFHVKPLE KAQLKNWKEY LEFEIENGTH ERVVVLFERC VISCALYEE (1-348 aa encoded by BC125126 )
靶标信息
The PRPF39 gene plays a critical role as a splicing factor involved in alternative splicing regulation. In humans, it is homologous to the yeast Prp39 and Prp42 paralogs, forming a homodimer that interacts with the carboxy-terminal domain (CTD) of U1C, a parallel mechanism observed in the yeast Prp39/Prp42 heterodimer. Recent studies have highlighted its impact on splicing efficiency through knockdown experiments in HEK293 cells, which revealed significant changes in the expression of many genes, underscoring its importance in splicing adaptability according to cell type-specific needs. Additionally, PRPF39 is found to be highly expressed in Acute Lymphoblastic Leukemia (ALL), with research suggesting that targeting PRPF39 for degradation could contribute to the treatment of ALL. Phylogenetic analyses indicate a coevolution of PRPF39 expression with molecular components like shortened U1 snRNA, reflecting the splicing complexity across different species. The gene is also involved in the regulation of distant genes which are relevant to cellular responses, such as those involved in cisplatin response.
仅用于科研。不用于诊断过程。未经明确授权不得转售。
篇参考文献 (0)
生物信息学
蛋白别名: flj11128; flj20666; flj45460; mgc149842; mgc149843; Pre-mRNA-processing factor 39; PRP39 homolog; PRP39 pre-mRNA processing factor 39 homolog; unnamed protein product
基因别名: PRPF39
UniProt ID: (Human) Q86UA1
Entrez Gene ID: (Human) 55015